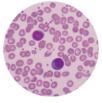

2025年山东省济南市槐荫区中考一模生物试题
山东精品2025
31道题
一、选择题
1
同学们用光学显微镜观察到如图所示几种组织细胞,其中具有细胞壁的是( )
A. | B. |
C. | D. |
2
关于细胞分裂及细胞分化的叙述,正确的是( )
| A.动植物细胞分裂时都是细胞质先一分为二 |
| B.细胞分裂和细胞分化后,遗传物质都有所改变 |
| C.癌细胞在各种因素影响下不断分裂而不分化 |
| D.经过细胞分化后,大部分细胞仍具有分裂能力 |
3
下列实验中,操作步骤与其目的对应正确的是( )
| 选项 | 实验名称 | 操作步骤 | 操作目的 |
| A | 练习使用显微镜 | 转换高倍物镜 | 使观察视野范围变大 |
| B | 比较不同果蔬维生素C含量 | 测试不同果蔬使用同一支试管 | 提高实验准确性 |
| C | 观察洋葱鳞片叶内表皮细胞 | 在载玻片中央滴一滴生理盐水 | 保持细胞正常形态 |
| D | 观察叶片的结构 | 用解剖刀迅速横切叶片 | 切取叶片组织 |
| A.A | B.B | C.C | D.D |
4
显微镜是科学研究中最常用的观察工具。图中操作流程正确的是( )

| A.③→①→②→④ | B.①→③→②→④ |
| C.①→②→③→④ | D.③→①→④→② |
5
如图为“验证绿叶在光下制造淀粉”的实验过程示意图。下列分析错误的是( )

| A.实验步骤的正确顺序为①③④② |
| B.③中用黑纸片遮盖部分叶片的作用是形成对照 |
| C.①的目的是将叶片内的淀粉运走耗尽 |
| D.④中小烧杯和大烧杯内的液体分别为清水和酒精 |
6
如图是绿色植物叶肉细胞的生理活动示意图,其中表述错误的是( )

| A.1过程只在白天进行,2过程只在晚上进行 | B.①表示的是叶绿体,②表示的是线粒体 |
| C.a表示的是二氧化碳,b表示的是有机物 | D.1过程能帮助生物圈维持碳一氧平衡 |